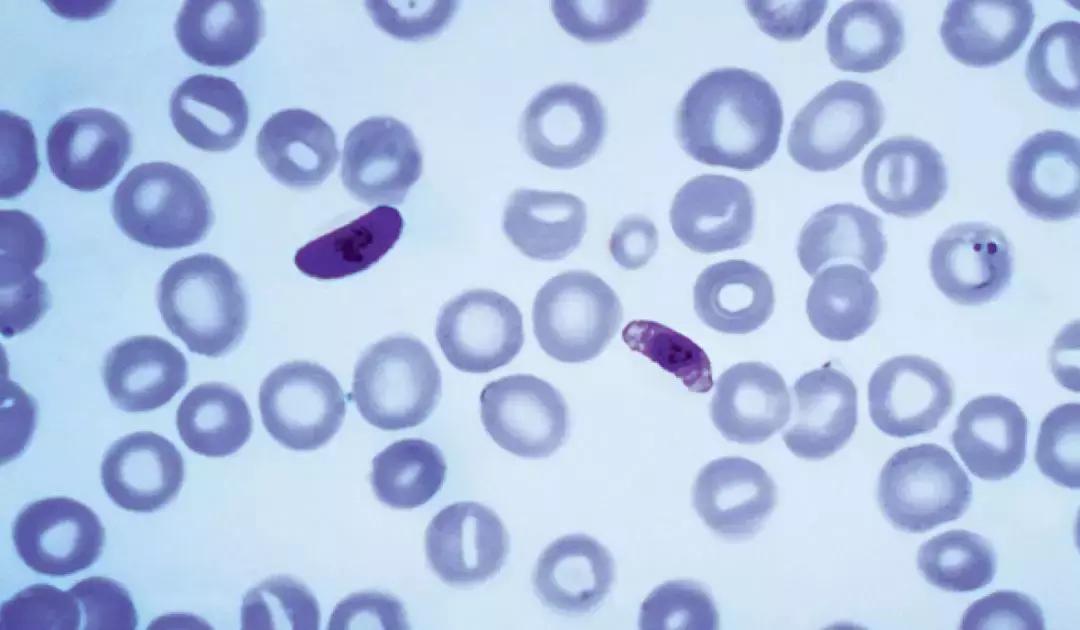
疟原虫抗癌疗法,疟原虫怎么治疗癌症

(视频截图)陈小平在“SELF格致论道”论坛上介绍“疟原虫治癌疗法”
起底“疟原虫治癌疗法”
文/彭丹妮
本文首发于总第888期《中国新闻周刊》
2018年12月23日,在中科院计算所旗下“SELF格致论道”举办的公开论坛上,中科院广州生物医药与健康研究所研究员陈小平发表了题为“疟原虫将成为抗癌生力军”的演讲,向公众介绍了他的“疟原虫治癌疗法”研究最新进展:“目前有近30例晚期癌症病人接受了疟原虫抗癌的治疗,10例已经观察了一年多,其中5例有效,2例可能已被治愈。”在他的描述中,治疗过程易如反掌:“我们给这个病人打1毫升含有疟原虫的血,这个治疗就完成了,就是打一针这么简单。”
疟原虫能治疗癌症的原因,陈小平在演讲中作了一个连初中生都能听懂的解释:因为癌细胞分泌一系列信号,让人类的免疫系统不工作;而疟原虫感染机体后,能唤醒免疫系统。同时,疟原虫还能抑制肿瘤血管生成,从而切断其营养供应。
癌症作为世纪难题,科研上的任何进展都牵动人心,更毋庸说陈小平直接提到了“治愈”二字。他的这番演讲,于一个月后被中科院官方微博转发,在春节期间立即吸引了众多自媒体及部分主流媒体的传播。但很快,来自同行与专业媒体的各种质疑声铺天盖地而来。
“疟疾疗法”前传
2017年9月,陈小平以杰出校友的身份回到母校广东医科大学作学术演讲,在那时,他就不遗余力地介绍他的疟疾与癌症的关系这套学说。广东医科大学前身为湛江医学院,陈小平于1977~1980年就读于此。据该校官网介绍,学制分5年制本科与3年制专科两种。后来,陈小平又在中山医科大学取得了硕士与博士学位。
2004年,中科院与广东省、广州市共建的广州生物医药与健康研究院成立后,当时已是广州市疾病预防控制中心艾滋病研究室主任的陈小平,成为该院第一批研究员并工作至今。
进入该院后,陈小平便集中精力从事疟原虫生物学和免疫学研究,“包括疟原虫与肿瘤的相互作用、疟原虫与艾滋病毒的相互作用研究”。陈小平一直津津乐道于该研究灵感的来源:1985年,他读研一时,从一幅疟疾在全球范围内的流行图与一幅肿瘤死亡率的分布图受到启发,“好像哪里多疟疾,哪里肿瘤的死亡率就低。可能疟原虫感染对肿瘤有治疗作用。”在演讲视频中,他将自己描绘成一名坚持理想不为外界所动的科学勇士,宣称“我毕生的梦想与追求就是战胜癌症,希望疟原虫免疫疗法能够推广到全球”。
然而,种种公开信息却显示,陈小平并非是第一个也不是唯一一个想到用疟原虫来治病的人,而该领域最有名的“先驱”、已经于2016年去世的亨利·海姆立克,与陈小平有着千丝万缕的联系。

疟原虫疗法“先驱”亨利·海姆立克
海姆立克是一名美国外科医生,因发明了“海姆立克急救法”,被称为“挽救生命最多的外科医生”,但在西方却有大量负面报道。他的儿子皮特·海姆立克谴责其一生是“50年未曾被发现的到处行骗史”。
皮特搜集了大量资料与报道,起底自己父亲这位“了不起的连环*子骗**”。其中,他特别提到,“我父亲最怪异的事莫过于‘疟疾疗法’,一个宣称通过感染疟疾来治愈癌症、艾滋病和莱姆病的*局骗**。”
利用引起疟疾的疟原虫来治病也不是海姆立克的发明。1917年,奥地利医生朱利叶斯·瓦格纳-尧雷格发现,疟原虫感染引起的发烧能够治疗梅毒。瓦格纳-尧雷格因此获得了1927年的诺贝尔医学奖。1940年代,青霉素发明后,梅毒的疟原虫疗法便退出了历史舞台。
海姆立克却在1980年代重新拾起了这种疗法。据美国杂志《新共和》2007年报道, 海姆立克的第一个目标就是癌症——尽管他毫无肿瘤学的背景。《华尔街日报》1982年第一次公开报道了海姆立克关于疟疾抗癌的想法。美国疾控中心、食药监局等均拒绝疟原虫疗法,并与其他医学专业人士及*权人**活动人士一起谴责其*行暴**。
由于得不到支持,海姆立克曾于1987年前往墨西哥进行推广,结果5个患者中,有4个接受治疗不到一年便去世。海姆立克不但没有放弃,却转而开始将疟疾疗法应用在莱姆病和艾滋病患者身上。这些治疗都不成功,且继续招致批评:疗法被认为毫无科学依据,并有生命危险。
海姆立克并未停止他大胆的试验。据《好莱坞记者报》等报道,他利用明星们的捐赠作为经费来源,开始在中国寻找合作伙伴,陈小平便是其中之一。《纽约时报》2003年的一篇报道指出,1993~1996年期间,海姆立克的疟疾治疗艾滋病项目在中国进行试验,他与陈小平为首的几位中国科研人员合作,在至少8位中国艾滋病人身上注射了含疟原虫的血液。其中有7人是来自云南的毒贩。事后,参与该项研究的多位美国研究人员受到美国监管机构的调查。这些研究被世界卫生组织称为“残忍的罪行”。
陈小平与海姆立克的合作不仅于此。一篇于1999年发表在《浙江肿瘤》上的文章《疟疾疗法治疗晚期肿瘤的初步报告》显示,陈小平与海姆立克等人当时就已经进行了疟疾治癌的临床试验,选择了7例晚期癌症患者作为受试者。
该研究是在美国Rippel基金的资助下进行的。Rippel基金会是海姆立克的一个长期资助者,由美国一位金融家于1953年成立。此外,陈小平1998年博士论文即为研究疟原虫与HIV的相互作用和关系,而亨利·海姆立克则出现在他的指导老师小组名单中。
20年后,当陈小平在国内公开推介他的疟原虫疗法时,却只字不提这位与他有过密切合作、在国际上声名狼藉的先行者。一个在国外被业界频频批评和被媒体多次曝光的疗法,在近30年后,依然在中国找到了生存空间。
对此,浙江大学生命科学学院教授王立铭引用《经济学人》于1月31日发表的一篇评论文章分析说,要警惕一种现象:“伦理倾销”——那些更富裕、监管更严格国家的科学家,将本国不被允许的医学研究搬到另一个可能较穷、监管较为松懈的国家去进行——已经成为相当普遍的现象。”
疟原虫的各种研究互相矛盾
《中国新闻周刊》通过检索中国知网发现,国内关于疟原虫与癌症之间关系的研究极其有限;而国外医学界在这方面已有较多高质量的研究成果,但陈小平的研究与已发表的文献存在诸多相悖之处。
陈小平对1955~2008年间全球56个国家中30种癌症死亡率和这些国家的疟疾发病率进行了比较,结果发现,疟疾发病率与全球癌症死亡率可能负相关。这一研究于2017年发表在《Infect Agent Cancer》期刊上。对此,王立铭分析说,整体而言,两个趋势之间的负相关性是非常微弱的。疟疾发病率变成原来的2倍,癌症发病率只会降低10%左右。
有学者直言,疟原虫与癌症二者之间并不存在直接关系,或关系很弱——更糟糕的是,目前学界研究发现,疟疾被证实会增高某种癌症的发病率。
丹麦哥本哈根大学免疫学与微生物学研究中心教授Ali Salanti以及温哥华前列腺癌研究中心的MadsDaugaard等人对于疟疾与癌症的关系作过研究。Ali Salanti接受《中国新闻周刊》采访时表示,“我们并不是很熟悉陈小平所作的研究,但我可以说,癌症与疟疾没有关系,除了伯基特淋巴瘤——同时感染埃博拉病毒与疟疾会促使肿瘤增大。除此之外,非洲关于疟疾流行病学的数据并没有显示二者之间有明显关联。”

非洲关于疟疾流行病学的数据,并没有显示疟疾与癌症之间有明显关联
过去50多年,医学界已经发现疟疾流行地区同时有伯基特淋巴瘤高发的情况,这是一种具有地方流行性的儿童期癌症,多发于非洲地区。2015年8月,美国洛克菲勒大学Davide Robbiani等学者在《Cell》上发表文章揭开了疟疾致癌的机制:小鼠试验表明,在长期对抗恶性疟原虫的过程中,B细胞DNA变得容易发生致癌突变。
关于疟原虫治癌的原理,陈小平解释说,疟原虫感染可以非常强烈地激活天然免疫细胞(NK细胞),这种细胞激活后可以杀灭一部分肿瘤细胞。当肿瘤细胞死亡后,它释放的抗原跟疟原虫感染同时存在的情况下,激活了T细胞。“我们知道,T细胞是抗病原体和抗癌的主力军,T细胞被激活,特别是肿瘤内部的T细胞被激活,可以非常有效地杀灭癌细胞。”
而疟原虫作为毒性病原体,能否真的激活免疫系统,似乎也并不那么理所当然。“一个由来已久的看法是,激活癌症患者的免疫系统在有些情况下能够促使免疫系统去攻击肿瘤。一些科研人员也成功地研制出使用病毒激活患者的免疫系统。”但Ali Salanti强调说,“疟原虫与病毒不同的是,它可以在人体内存活很长一段时间,这恰恰就因为它特别不擅长激活免疫系统。
因此,我并不看好在人体身上注射(疟原虫)这个试验可以实现(免疫系统)的激活。”霍普金斯医学院肿瘤系的一位遗传学博士也撰文指出,诸多研究文献已经表明,疟原虫感染甚至会抑制免疫系统。
该疗法的另一个生物学机制,陈小平声称,是疟原虫激活了免疫细胞的同时,还可以抑制肿瘤血管生成,从而切断营养供应,“饿死肿瘤细胞”。具体而言,疟原虫可以通过下调VEGF(血管内皮生长因子)的受体蛋白VEGFR-2,来阻断血管生成的信号通路。该研究成果于2017年发表在杂志《Oncogenesis》 上。
显微镜下的疟原虫。陈小平的疟原虫治癌原理中有诸多问题需要解答,比如并未比较各种毒性不同的疟原虫是不是同样有效等等。
然而,日本东京大学医学部研究人员2010年发表的研究结论则与之相反:恶性疟原虫和间日疟原虫感染导致人体的VEGF和VEGFR-2上调。
研究除了在理论模型上招致许多批评,多位业内专家并不认同陈小平对其临床试验结果的阐释方式,认为这不仅是不科学的,甚至会误导公众。在肿瘤的临床治疗中,一般只有症状完全缓解、并持续五年的病例,才能称为临床治愈。
“从网上公布的临床结果来看,并没有证据表明这种治疗方式产生的效果超过现有的其他治疗方法。事实上,如果用严格的现代肿瘤治疗疗效评价标准来衡量,网上公布的现有10位病人接受一年治疗的结果,并不能证明这是一种有效的疗法。”美国耶鲁大学肿瘤中心免疫学主任、PD-1免疫疗法理论的重要贡献者陈列平在接受《中国新闻周刊》采访时表示。
此外,一个不容忽略的科学事实是,多篇文献提示,抗疟药物对癌症治疗有效。例如,宾夕法尼亚大学研究人员2017年在《Cancer Discovery》上发表的文献就指出,一种叫做DQ661的药物能够有效靶向PPT1这个酶分子,同时阻断调节癌细胞生长的mTOR和细胞自噬,而DQ661实际上是抗疟药物氯喹的二聚体形式。《中国新闻周刊》检索美国临床试验网发现,目前用抗疟药物青蒿素或氯喹治疗癌症的临床试验已共计20多个。
从陈小平疟原虫疗法临床试验的过程描述来看,受试者在出组时会被注射氯喹或者青蒿素以灭虫,因此,部分受试者的“治愈”或归功于抗疟药物而非疟疾本身;同时,这个结论也会削弱疟疾发生率与癌症死亡率负相关的论断,因为在疟疾流行的地区,抗疟疾药物的使用自然也更加广泛。
针对上述疑点,《中国新闻周刊》多次联系陈小平本人,电话均无人接听。
中国工程院院士、呼吸病学家钟南山也是该研究的参与者之一。在项目位于广州医科大学附属第一医院的第一个临床试验基地,钟南山和陈小平分别担任临床研究小组的组长和副组长。
“尚没有充分的证据和足够数量的案例证实该方法有效,个别案例不足以说明问题。”钟南山2月8日接受央视采访时表示:“目前该项研究仍有很多未知数,但是这个现象已经很肯定了。”他进一步说明,未来科研团队将提取疟原虫生物介质,进行更深入的研究。不通过自然发生疟疾的方法,而是通过有效的生物介质来激发体内的自然发生细胞的活性。
存疑的伦理审查
从2016年起,陈小平团队连续与广州医科大学附属第一医院、暨南大学附属广州复大肿瘤医院和云南昆钢医院合作,展开临床研究。除了最早的一批受试者,也就是在陈小平演讲中提到的已有结论的有10人,目前还有30多人在等候人体试验。
多位业内人士指出,除了试验本身的科学原理站不住脚,陈小平的临床试验还存在较大健康风险:受试者被注射病原体,可能会带来的身体伤害;疟疾作为世界三大传染病之一,试验可能会引起疟疾传播进而危及公众安全。
以高烧为例,陈小平曾告诉媒体,“患者会颇有规律地,每隔一天发一次高烧,高至39℃甚至40℃,约两个月以后,病人不再发烧。”但广州医科大学附属第一医院的一位受试者告诉《中国新闻周刊》,她与另一位受试者都连续高烧,并出现感染。她的日记写道,“接种一个月左右,出现持续高烧不退的情况,并伴随咳嗽,整夜睡不着的情况,持续时间大概半个月。”
陈小平认为,能够为其伦理及试验风险辩护的一个重要理由是:受试患者已是癌症晚期,无他法可试,且在患者及家属同意下采用这种方法。对此,北京协和医学院人文和社会科学学院院长翟晓梅指出,晚期绝症患者的这种脆弱性很容易被利用,“科学家与医生是专业人员,我们不能利用公众的这种脆弱性与迫切性,我们应该有保护他们的责任心。”
“我们要经过非常严谨的评估,评估除了它有效没效之外,还要看它的风险与收益,目前有没有其他更好的方法代替,会不会引起其他的大的一些问题等等……这些都是必须经过严格评估之后才会来作临床试验。”广东省肺癌研究所所长、广东省人民医院终身主任吴一龙解释说。
根据国家卫计委《涉及人的生物医学研究伦理审查办法》,伦理委员会由开展生物医学研究的医疗卫生机构设立,且成员应当从生物医学领域和伦理学、法学、社会学等领域的专家和非本机构的社会人士中遴选产生,人数不得少于7人。
与企业发起的药物临床试验不同,研究者发起的临床试验只需要在相关临床试验管理部门备案,经由医院内部自行组织的专业和伦理委员会批准,就可开展。王立铭认为,由于较为宽松的申请和注册门槛,研究者发起的临床试验,“确确实实存在被滥用的可能”。
广州医科大学附属第一医院伦理委员会提供的该试验的《临床试验会议审批件》显示,其伦理委员会由11人组成,包括该医院的9位成员、一位社会律师以及越秀区计生办科长。另外两个试验伦理委员会未提供相关信息。
但多位专家告诉《中国新闻周刊》,问题不仅在于程序规范与否,更重要的是,伦理委员会是否有足够的能力来起到把关的作用,尤其是面对具有挑战性的研究项目,需要委员会成员有深入的知识。“这种人文、伦理的问题,对我们很多人来讲都很生疏。伦理委员会的组成不是随便就几个人来就可以,它应当经过非常严格的培训。”吴一龙表示。
伦理委员会是否进行过充分的科学论证,基于什么理由同意该试验?就这些问题,《中国新闻周刊》多次尝试与三家医院临床试验的伦理委员会取得联系,但截至发稿时都未得到回应。
在演讲中,陈小平透露说,“从申请临床试验再到批准历经了3年的伦理答辩,这是相当不容易的。”陈小平在接受《广州日报》采访时曾透露,在2016年注册的第一个临床试验中,疟原虫疗法经广州医科大学附属第一医院伦理委员会组织的多次伦理答辩,且多次修改方案后,才开始在晚期癌症患者身上进行试验。
翟晓梅表示,业界不仅要关注这个研究如何通过伦理审查,亦即“程序合法问题”,还应该关注更实质的科学价值问题:伦理审查委员会讨论一个科研项目的时候,首先要讨论实质伦理的问题,包括研究该不该做、是否有价值等。“现在越来越多的事实判断告诉我们,他这个研究在科学上是存在很多问题的。如果是这样的话,那么伦理学上的价值判断应首先受到质疑。”
另一个招致批评的问题是,陈小平的临床试验结果尚未在经同行评议的学术期刊上发表,就在公众平台上传播。“证据还不十分可靠的时候,就以一个突破性的进展,以一个完全可靠的、确定的一个事实报道给媒体,这种做法是不妥的。”翟晓梅指出,公众因为对研究的不了解,以为问题已经得到解决,晚期癌症患者就会应声蜂拥而去,结果可能会伤害受试者,长远来看会伤害公众对科学界的信任。
“医学进步不能营销希望,医学进步需要最高标准的透明度和同行评审,”复旦大学肿瘤学博士、复旦大学附属肿瘤医院泌尿外科副主任医师朱耀告诉《中国新闻周刊》,“透明度是保证成功可以复制,同行评审是保证内行看门道。”
疟原虫治癌背后的商业
从疟原虫抗癌疗法的受试者招募到临床试验,一直都有广州中科蓝华生物科技有限公司(以下简称“中科蓝华”)的身影。该公司官网信息显示,陈小平自2013年起担任公司创始人、CEO。
工商资料显示:中科蓝华于2013年成立,注册资本1900万元,最大股东及实际控制人为柯宗贵(持股比例为64%),柯宗贵也是创业板A股上市公司蓝盾信息安全技术股份有限公司的最大控股股东。但从蓝盾股份最新的财报来看,中科蓝华并未贡献营收。
该公司在介绍中声称掌握四大原创核心技术,均与疟原虫有关。对于疟原虫治癌新技术,官网介绍“具有非常诱人的前景”,而其开发的新型抗疟疾药物DQ,“其体外抗疟效果优于青蒿素10倍。”
中科蓝华拥有三家全资子公司:广州蓝锦生物科技有限公司,主要经营癌症的疟原虫免疫疗法,并将成为临床研究的CRO(医药研发合同外包服务机构)公司;广州蓝亮医药科技有限公司,主要从事新型抗疟药的研发;广州蓝耀医药科技有限公司,主要从事癌症免疫治疗的宣传教育与推广。三家子公司分别成立于2015年、2016年、2017年,陈小平均担任经理一职。
癌症免疫疗法的市场热潮以及政府对生物科技行业的政策支持,让中科蓝华这类创新企业找到了“野蛮生长”的土壤。肿瘤免疫疗法,即通过刺激患者自身的免疫系统攻击肿瘤细胞,被视为化疗、放疗和靶向治疗后,癌症治疗领域的第三次革命。詹姆斯·艾利森与本庶佑由于发现免疫抑制机制,找到治疗肿瘤的新方法,荣获2018年诺贝尔生理学或医学奖,该疗法在当前医学领域中的地位可见一斑。
“现在国家的创新大环境很好,创新新政策、新机制不断出台,也允许科学家办企业了,这些都为科学家创造了很多有利条件。”陈小平2018年接受媒体采访时曾谈到外部环境对创新的作用。中科院广州生物医药与健康研究院副书记侯红明2018年5月造访中科蓝华时指出,在国家对生物医药高新技术的政策支持下,广州生物院孵化出的高新技术及各项专利逐步与企业接轨合作,实现除了发表学术论文以外的技术产业化的实践道路。
据公开报道,2017年10月19日,中科蓝华宣布与上海思科瑞新签署战略合作协议,后者为中科蓝华注资数千万元。柯宗贵同时透露:“中科蓝华还要在肺、肝等领域继续做工作,也准备去纳斯达克上市。”2018年10月,柯宗贵再次表态:“中科蓝华正在探索攻克晚期实体肿瘤治疗的世界难题,把以疟原虫免疫疗法为基础的癌症治疗整体解决方案做成癌症免疫疗法领域的独角兽,准备两年左右的时间在香港筹备上市。”
毕业于电子工程系并长期掌舵一家主营信息安全技术公司的柯宗贵,显然对陈小平的疗法非常乐观。他的乐观也有现实做支撑:在陈小平受到业界强烈质疑之后,2019年2月14日凌晨,中科蓝华招募晚期癌症患者参加临床试验的帖子,依然突破了10万+的浏览量。有人在网上评论说,“如果有机会,大部分癌症晚期患者还是愿意试一试吧。比起等死,既可以有机会康复,又可以为医学作贡献。传播未证实的消息是不好,但希望这不是谣言,而是希望。”
“PD-1是特异性免疫,即通路与机制相对明确,而‘疟疾抗癌’属于非特异性免疫,具体通路、机制均尚不明确。”上海交通大学医学院附属仁济医院肿瘤科主任王理伟接受媒体采访时指出。美国耶鲁大学肿瘤中心免疫学主任陈列平则直言,“对一种尚未显示出明确效果的临床试验方法,探讨它的原理和前景是没有多大意义的。”